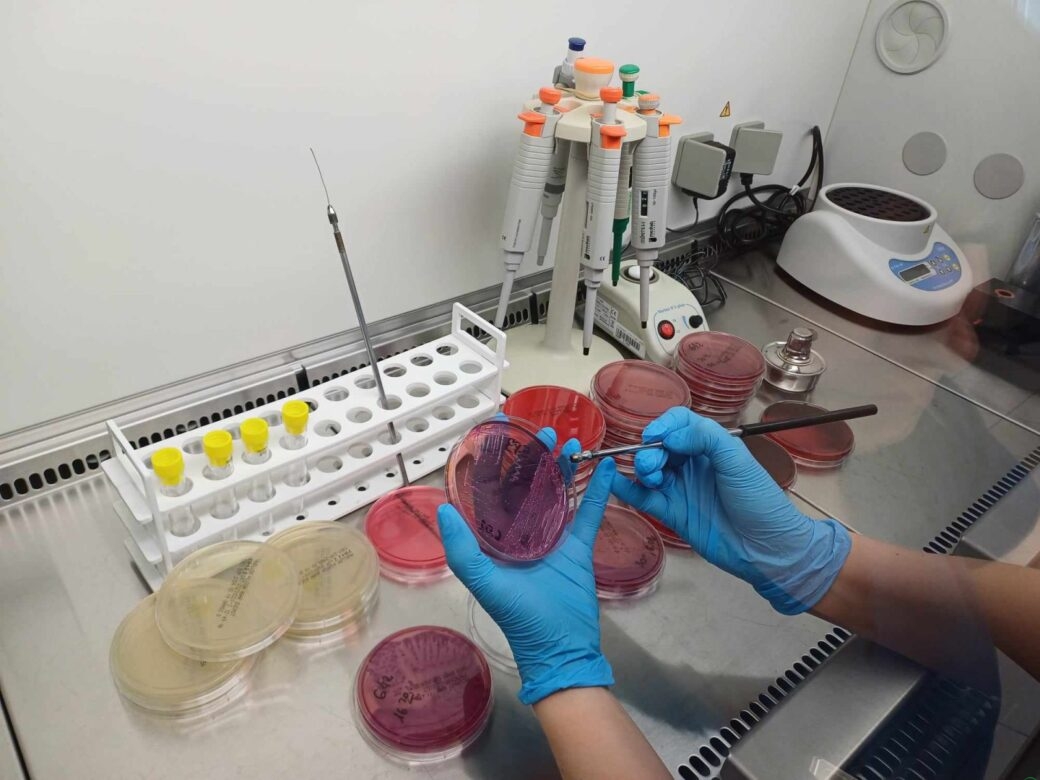

Badania laboratoryjne są jednym z kluczowych elementów współczesnej diagnostyki medycznej, stanowiąc podstawę decyzji dotyczących rozpoznania chorób, doboru terapii oraz monitorowania jej skuteczności. Z tego względu laboratoria medyczne podlegają regularnym, zewnętrznym ocenom jakości. Jedną z nich pomyślnie przeszły Laboratoria American Heart of Poland działające w Bielsku-Białej i Ustroniu, uzyskując pozytywną ocenę Centralnego Ośrodka Badań Jakości w Diagnostyce Laboratoryjnej.
Zewnętrzna ocena jakości badań laboratoryjnych
Centralny Ośrodek Badań Jakości w Diagnostyce Laboratoryjnej, działający przy ministrze zdrowia, realizuje ogólnopolskie programy oceny jakości badań laboratoryjnych, obejmujące różne dziedziny diagnostyki.
Laboratoria American Heart of Poland w Ustroniu oraz Bielsku-Białej uzyskały pozytywną ocenę w programach realizowanych przez COBJwDL, co potwierdza zgodność prowadzonych badań z przyjętymi standardami jakości.
W ramach programów Centralnego Ośrodka Badań Jakości w Diagnostyce Laboratoryjnej do laboratoriów w całym kraju trafiają losowo wybrane próbki kontrolne. Wyniki ich oznaczeń są następnie analizowane i porównywane z wartościami referencyjnymi oraz obowiązującymi kryteriami jakości. Udział w tego typu programach pozwala na bieżąco monitorować poprawność wykonywanych badań oraz identyfikować obszary wymagające doskonalenia.
Diagnostyka mikrobiologiczna pod kontrolą jakości
Odrębnym elementem zewnętrznej weryfikacji jakości jest Ogólnopolski Sprawdzian Wiarygodności Badań Mikrobiologicznych POLMICRO. Program ten koncentruje się na ocenie poprawności identyfikacji drobnoustrojów oraz interpretacji wyników badań mikrobiologicznych.
W edycji POLMICRO 2025 pozytywny wynik uzyskała pracownia mikrobiologii działająca w Ustroniu.
Jak podkreśla Artur Gabrysiak, manager medycyny laboratoryjnej American Heart of Poland, udział w tego typu sprawdzianach pozwala na obiektywną ocenę pracy laboratoriów oraz potwierdzenie kompetencji zespołów diagnostycznych.
Znaczenie jakości dla praktyki klinicznej
Systematyczna kontrola jakości oraz udział w ogólnopolskich programach sprawdzających są jednym z elementów zapewniania bezpieczeństwa pacjentów i utrzymania wysokiego poziomu diagnostyki laboratoryjnej.